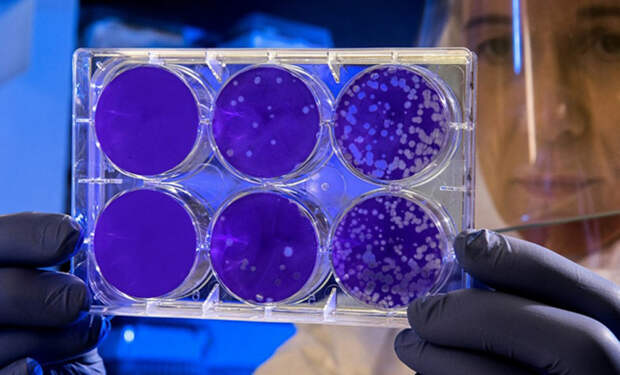
2 2

Исследователи из Южной Кореи и США обнаружили, что один из белков, участвующих в структуре ДНК — HMGB1, может запускать процессы старения в здоровых клетках, если он попадает в кровь в особой форме. Результаты опубликованы в журнале Metabolism.

HMGB1 обычно находится внутри клеточного ядра и помогает организовывать генетический материал. Однако при старении или стрессе клетки этот белок выходит наружу, где начинает действовать иначе. В зависимости от уровня кислорода он может становиться либо окисленным, либо восстановленным. Восстановленная форма, как показали эксперименты, запускает процесс сенесценции — прекращение деления и воспаление в здоровых клетках.
Ученые провели эксперименты на клетках почек, легких, мышц и кожи человека. При контакте с восстановленным HMGB1 клетки начинали стареть, прекращали делиться и выделяли воспалительные сигналы. При этом контакт с окисленным белком не вызывал подобных изменений — клетки продолжали функционировать нормально.
Эффект подтвердился и на животных. Молодым мышам вводили небольшое количество восстановленного HMGB1. Уже через неделю у них наблюдались признаки преждевременного старения — воспаление и клеточные изменения, характерные для пожилого возраста.

Кроме того, при анализе крови пожилых людей (70–80 лет) и мышей исследователи обнаружили значительно более высокий уровень восстановленного HMGB1 по сравнению с людьми сорока лет и молодыми животными.
Что может влиять на HMGB1 на основе текущих исследований
Нейтрализующие антитела к HMGB1
В экспериментах на мышах блокировка экстрацеллюлярного HMGB1 с помощью специальных антител снижала маркёры старения и улучшала функциональное восстановление тканей
Глицирризиновая кислота (Glycyrrhizic acid, GA)
В исследованиях, касающихся клеток сетчатки (RPE), было показано, что GA напрямую связывается с HMGB1 и предотвращает его выделение во внеклеточное пространство, что смягчает вызванную этим старческую трансформацию клеток.
Метформин (Metformin)
Из докладов известно, что метформин, широко используемый препарат при диабете 2 типа, блокирует транслокацию HMGB1 из ядра, сопровождающую старение стволовых клеток, тем самым подавляя сенесценцию.
По словам одного из авторов исследования, Ок Хи Джон из Korea University College of Medicine, сигналы старения могут распространяться системно через кровь, а не ограничиваться отдельными клетками.
Результаты исследования могут стать основой для разработки новых методов замедления старения, направленных на блокировку действия восстановленного HMGB1. Ученые считают, что контроль уровня этого белка в крови может в будущем использоваться для диагностики и лечения возрастных изменений.
источник

HMGB1 обычно находится внутри клеточного ядра и помогает организовывать генетический материал. Однако при старении или стрессе клетки этот белок выходит наружу, где начинает действовать иначе. В зависимости от уровня кислорода он может становиться либо окисленным, либо восстановленным. Восстановленная форма, как показали эксперименты, запускает процесс сенесценции — прекращение деления и воспаление в здоровых клетках.
Ученые провели эксперименты на клетках почек, легких, мышц и кожи человека. При контакте с восстановленным HMGB1 клетки начинали стареть, прекращали делиться и выделяли воспалительные сигналы. При этом контакт с окисленным белком не вызывал подобных изменений — клетки продолжали функционировать нормально.
Эффект подтвердился и на животных. Молодым мышам вводили небольшое количество восстановленного HMGB1. Уже через неделю у них наблюдались признаки преждевременного старения — воспаление и клеточные изменения, характерные для пожилого возраста.
Кроме того, при анализе крови пожилых людей (70–80 лет) и мышей исследователи обнаружили значительно более высокий уровень восстановленного HMGB1 по сравнению с людьми сорока лет и молодыми животными.
Что может влиять на HMGB1 на основе текущих исследований
Нейтрализующие антитела к HMGB1
В экспериментах на мышах блокировка экстрацеллюлярного HMGB1 с помощью специальных антител снижала маркёры старения и улучшала функциональное восстановление тканей
Глицирризиновая кислота (Glycyrrhizic acid, GA)
В исследованиях, касающихся клеток сетчатки (RPE), было показано, что GA напрямую связывается с HMGB1 и предотвращает его выделение во внеклеточное пространство, что смягчает вызванную этим старческую трансформацию клеток.
Метформин (Metformin)
Из докладов известно, что метформин, широко используемый препарат при диабете 2 типа, блокирует транслокацию HMGB1 из ядра, сопровождающую старение стволовых клеток, тем самым подавляя сенесценцию.
По словам одного из авторов исследования, Ок Хи Джон из Korea University College of Medicine, сигналы старения могут распространяться системно через кровь, а не ограничиваться отдельными клетками.
Результаты исследования могут стать основой для разработки новых методов замедления старения, направленных на блокировку действия восстановленного HMGB1. Ученые считают, что контроль уровня этого белка в крови может в будущем использоваться для диагностики и лечения возрастных изменений.
источник
Свежие комментарии